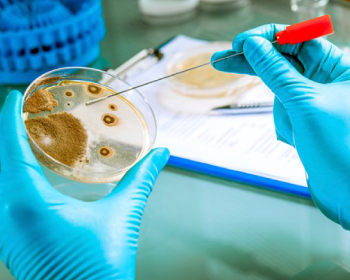
modulo-01

*Cupo limitado a 60 participantes por fecha.
La Microbiología de Alimentos es una rama de la microbiología que trata acerca de los procesos en que los microorganismos influyen dentro de las características de los productos de consumo alimenticio humano o animal. El Diplomado en Microbiología de los Alimentos está dirigido a estudiantes que desean ampliar y desarrollar conocimientos sobre la microbiología de alimentos con la finalidad de que al concluir el diplomado los participantes tengan la capacidad de analizar el significado de los microorganismos en los alimentos. El Diplomado Internacional en Microbiología de los Alimentos se encuentra Certificado con 40 puntos de valor curricular por la World Federation for University Education, además se encuentra avalado por la STPS (Sistema de Registro de la Capacitación Empresarial SIC110307957-0013).
Objetivo General +
Objetivos Específicos +
Conocer las diferentes formas de utilizar la microbiología para la creación de alimentos.
Analizar los procesos de la microbiología en el desarrollo de alimentos.
Conocer acerca de la evaluación de riesgos en la contaminación microbiológica en un alimento.
Metodología +
Uso de equipo audiovisual interactivo para ampliar conocimientos en Microbiología de Alimentos.
Taller teórico práctico para conocer cómo analizar los microorganismos en los alimentos.
Certificación +

| Precios y Descuentos | ¡Regístrate Ahora! |